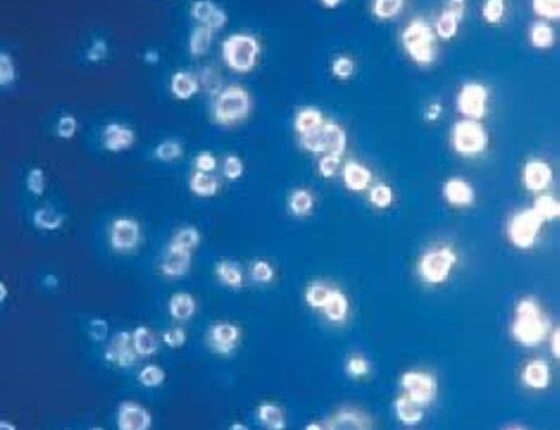

Τα νανοδιαμάντια στη μάχη ενάντια στον καρκίνο του μαστού
Τα νανοδιαμάντια ως «διανομείς» φαρμάκων, μπορούν να βελτιώσουν κατά πολύ την αποτελεσματικότητα της θεραπείας του καρκίνου του μαστού.
Πρόσφατα οι γιατροί ξεκίνησαν να κατηγοριοποιούν τον καρκίνο του μαστού σε τέσσερις βασικές κατηγορίες, ανάλογα με το γενετικό υλικό των καρκινικών κυττάρων. Η κατηγορία στην οποία ανήκει ο καρκίνος καθορίζει σε γενικές γραμμές ποια είναι η καλύτερη μέθοδος θεραπείας γι’ αυτόν.
Ωστόσο, μία απ’ αυτές τις κατηγορίες, που ονομάζεται «τριπλά αρνητικός καρκίνος μαστού» (TNBC) είναι ιδιαίτερα δύσκολο να θεραπευτεί, επειδή συνήθως δεν ανταποκρίνεται στις θεραπείες που είναι στοχευμένες στους υποδοχείς, όπως συμβαίνει με τις άλλες κατηγορίες. Ο TNBC τείνει να είναι περισσότερο επιθετικός από τους άλλους τύπους καρκίνου και πολλές φορές επανεμφανίζεται, ενώ έχει και το υψηλότερο ποσοστό θνησιμότητας.
Ευτυχώς, όμως, περισσότερο αποτελεσματικές θεραπείες βρίσκονται πια στον ορίζοντα. Ερευνητές του Πανεπιστημίου του Λος Αντζελες με επικεφαλής τον Ντιν Χο, καθηγητή της Οδοντιατρικής και συν-διευθυντή στο Κέντρο Επανορθωτικής Βιοτεχνολογίας, έχουν αναπτύξει μία δυνητικά περισσότερο αποτελεσματική θεραπεία για τον TNBC που χρησιμοποιεί μια νανοκλίμακα με σωματίδια που μοιάζουν με διαμάντια και ονομάζονται νανοδιαμάντια.
Τα νανοδιαμάντια έχουν διάμετρο 4-6 νανόμετρα και σχήμα μικροσκοπικής μπάλας ποδοσφαίρου. Μέσα από διαδικασίες συμβατικής εξόρυξης και διύλισης, τα σωματίδια αυτά μπορούν να δημιουργήσουν συστάδες που ακολουθούν το αντικαρκινικό φάρμακο και έχουν την ικανότητα να το παραδώσουν στον όγκο, βελτιώνοντας σημαντικά την αποτελεσματικότητά του. Στη μελέτη του UCLA το σύστημα παράδοσης των νανοδιαμαντιών κατάφερε να εισχωρήσει στη μάζα των όγκων σε ποντικούς με τριπλά αρνητικό καρκίνο του μαστού.
Τα αποτελέσματα της μελέτης δημοσιεύτηκαν στο περιοδικό Advanced Materials. «Αυτή η μελέτη δείχνει την ευελιξία των νανοδιαμαντιών ως διανομέων φαρμάκων σε έναν καρκινικό όγκο», είπε ο Χο, που είναι επίσης μέλος του Ινστιτούτου Νανοσυστημάτων του Πανεπιστημίου του Λος Αντζελες. «Ο παράγοντας που αναπτύξαμε μειώνει τις τοξικές παρενέργειες που συνδέονται με τη θεραπεία και μεσολαβεί για τη σημαντική μείωση του μεγέθους του όγκου».
Η ερευνητική ομάδα συνδύασε διάφορα σημαντικά συστατικά καταπολέμησης του καρκίνου στην επιφάνεια των νανοδιαμαντιών, συμπεριλαμβανομένης της επιρουβικίνης, μιας ιδιαίτερα τοξικής αλλά ευρέως χρησιμοποιούμενης χημειοθεραπευτικής αγωγής που συχνά χορηγείται σε συνδυασμό με άλλα αντικαρκινικά φάρμακα. Η νέα ένωση προσδέθηκε σε ένα υλικό κυτταρικής μεμβράνης επικαλυμμένο με αντισώματα που στόχευσαν απευθείας στον υποδοχέα που παρουσιάζει υψηλή συγκέντρωση στις επιφάνειες των κυττάρων του TNBC. Το αποτέλεσμα ήταν η δημιουργία ενός συστήματος διανομής φαρμάκων, η νανοδιαμαντο-λιπιδο-υβριδική ένωση (NDLP).
Οταν αυτός ο παράγοντας χρησιμοποιήθηκε στους ποντικούς έδειξε ότι μειώθηκε σημαντικά η αύξηση του όγκου και εξαλείφθηκαν οι καταστροφικές παρενέργειες της αντικαρκινικής θεραπείας.
Λόγω της μεγάλης τοξικότητάς της η επιρουβικίνη όταν χορηγείται μόνη της μπορεί να δημιουργήσει σημαντικές παρενέργειες, όπως καρδιακή ανεπάρκεια και μείωση του αριθμού των λευκών αιμοσφαιρίων, ενώ έχει συνδεθεί με αυξημένο κίνδυνο ανάπτυξης λευχαιμίας. Στη μελέτη όλοι οι ποντικοί που τους χορηγήθηκε μόνο επιρουβικίνη πέθαναν πριν από την ολοκλήρωση του πειράματος. Αλλά οι ποντικοί στους οποίους χορηγήθηκε επιρουβικίνη μέσω του NDLP επιβίωσαν της θεραπείας και μάλιστα κάποιοι από τους όγκους μειώθηκαν τόσο που δεν ήταν πια ορατοί.
«Ο τριπλά αρνητικός καρκίνος του μαστού είναι πολύ επιθετικός και είναι εξαιρετικά δύσκολο να αντιμετωπιστεί, καθιστώντας εξαιτίας αυτής της δυσκολίας απαραίτητη την επιθετική χημειοθεραπεία», λέει ο Δρ Εντουαρντ Τσόου, ένας από τους συγγραφείς της μελέτης και επίκουρος καθηγητής στο Επιστημονικό Αντικαρκινικό Ινστιτούτο της Σιγκαπούρης.
«Η στόχευση και η αποτελεσματικότητα της θεραπείας με NDLP ήταν αξιοπρόσεκτη. Η ταυτόχρονη μείωση του όγκου και η βελτίωση της ανοχής των φαρμάκων αποτελεί ένδειξη που υπόσχεται πολλά για τη συνεχή ανάπτυξη των νανοδιαμαντιών με σκοπό την κλινική εφαρμογή τους. Η ερευνητική ομάδα τώρα μελετά την αποτελεσματικότητα και ασφάλεια του NDLP σε μεγαλύτερα ζώα».
Ενας επιπλέον ερευνητικός στόχος είναι ο προσδιορισμός του κατά πόσο τα νανοδιαμάντια μπορούν να ενισχύσουν την ανεκτικότητα ευρέως φάσματος συνθέσεων υψηλής τοξικότητας που θα μπορούσαν να βελτιώσουν τις υπάρχουσες θεραπευτικές αγωγές και τα αποτελέσματά τους. Αυτές οι ανακαλύψεις θα μπορούν να χρησιμεύσουν σαν πρόδρομοι για δοκιμές σε ανθρώπους, λένε οι ερευνητές.
«Τo NDLP που αναπτύχθηκε σ’ αυτή τη μελέτη είναι μια σπονδυλωτή πλατφόρμα», λέει η Λόρα Μουρ, μεταπτυχιακή φοιτήτρια στο εργαστήριο του Χο και συν-συγγραφέας της μελέτης. «Γι’ αυτό μπορούμε εύκολα να “δέσουμε” ένα ευρύ φάσμα από στοχευμένα αντισώματα και φαρμακευτικές συνθέσεις, για να αντιμετωπίσουμε αρκετές ασθένειες».
Ο Δρ Νο Χι Παρκ, πρύτανης της Οδοντιατρικής Σχολής του UCLA σημείωσε ότι η έρευνα θα προσφέρει μια βάση για μελλοντικές κλινικές εφαρμογές.
«Αυτή η πρωτοποριακή μελέτη παρέχει μεγαλύτερη κατανόηση των δυνατοτήτων του υλικού των νανοδιαμαντιών, για την αντιμετώπιση αρκετών ασθενειών», λέει ο Παρκ. «Πρόκειται για μια εργασία υψίστης σημασίας».